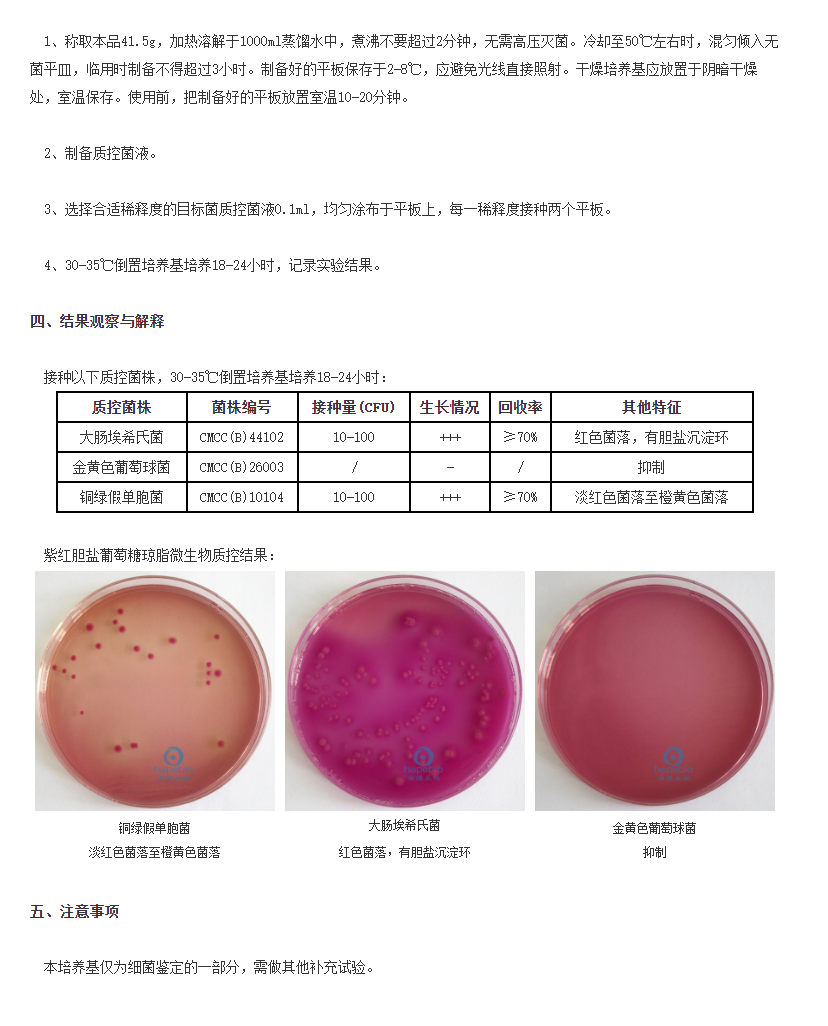

еуНГЃЧрЛЏЙЄЙЋЫОЪЧвЛМвМЏЩњВњЁЂУГвзЁЂЮяСїЮЊвЛЬхЕФЪЕбщЪвМьВтЗжЮізлКЯЗўЮёЧПЦѓЁЃжТСІгкЮЊгУЛЇЬсЙЉЧАбиЕФВњЦЗЁЂЙЄОпЁЂММЪѕКЭгІгУНтОіЗНАИЃЌЪЧПЭЛЇжЕЕУаХРЕЕФКЯзїЛяАщЁЃ
зюаТЩЬЦЗ
ЖЉдФЯћЯЂ
ФњНЋЕквЛЪБМфГЃЧрЕФзюаТЖЏЬЌЁЂВњЦЗИќаТЁЂММЪѕНјеЙвдМАаавЕзЪбЖЁЃ
COPYRIGHT 2023-2033 MYSITE LTD.ALL RIGHTS RESERVED.